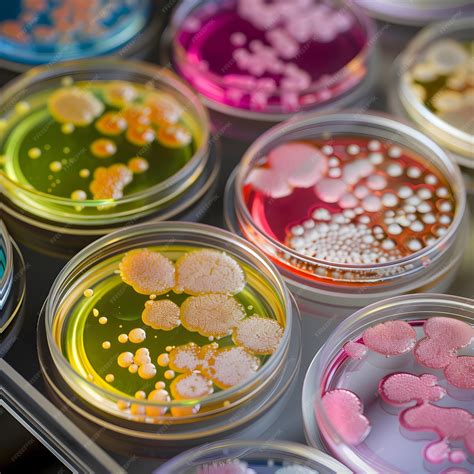
Microscopía de colonias de Legionella en un medio de cultivo

La presencia de Legionella en diversas instalaciones representa un desafío constante para la salud pública. La legionelosis, una enfermedad transmitida principalmente a través de la inhalación de aerosoles contaminados, puede acarrear consecuencias graves para la salud. En este contexto, la implementación de medidas de control y prevención rigurosas, junto con análisis exhaustivos del agua, se vuelve fundamental. La normativa vigente, como el Real Decreto 487/2022 y el Real Decreto 3/2023, establece la obligatoriedad de realizar controles periódicos y adoptar estrategias de prevención en instalaciones de riesgo, abarcando desde torres de refrigeración y sistemas de agua caliente hasta spas y fuentes ornamentales.

Marco Normativo y Obligatoriedad de Análisis
El Real Decreto 487/2022, de 10 de enero, sobre el control y prevención de la legionelosis, sienta las bases para la gestión de esta bacteria. Este real decreto establece la obligatoriedad de llevar a cabo controles periódicos y de implementar medidas preventivas en aquellas instalaciones que presenten un riesgo potencial de proliferación de Legionella. La lista de estas instalaciones es amplia e incluye, entre otras, las torres de refrigeración, los sistemas de agua caliente sanitaria, los circuitos de agua de piscinas y spas, y las fuentes ornamentales. La finalidad última de estas normativas es minimizar la exposición de la población a esta bacteria y, por ende, reducir la incidencia de la legionelosis.
Además de los controles específicos para Legionella, el Real Decreto RD 487/2022, en conjunto con el Real Decreto RD 3/2023, de 21 de junio, introduce la obligatoriedad de analizar conjuntamente otros microorganismos. Esto es particularmente relevante para ciertas tipologías de agua, como el agua de consumo humano o el agua de piscinas, donde se exige un análisis que incluya microorganismos aerobios y/o la presencia de hierro. Este enfoque ampliado busca ofrecer una visión más completa de la calidad microbiológica y fisicoquímica del agua, anticipando posibles problemas y garantizando su seguridad.
La Toma y Recogida de Muestras: Un Paso Crítico
La precisión de cualquier análisis microbiológico o fisicoquímico depende, en gran medida, de la correcta ejecución de la toma de muestras. El procedimiento varía significativamente en función del origen del agua y de la instalación de la que proviene. Es fundamental seguir las indicaciones específicas para asegurar que la muestra recolectada sea representativa y no sufra alteraciones durante el proceso.

Una vez obtenida la muestra, el etiquetado adquiere una importancia capital. Empresas especializadas como Control Bío se encargan de proporcionar las directrices necesarias para el etiquetado adecuado. Este proceso implica referenciar el recipiente de la muestra de manera precisa, ya sea utilizando un rotulador permanente o adhiriendo una etiqueta con la información requerida. Esta referenciación permite rastrear la muestra desde su origen hasta el laboratorio, garantizando la trazabilidad y la integridad de los datos.
La recogida de las muestras es otro eslabón esencial en la cadena de análisis. En muchos casos, empresas como Control Bío ofrecen servicios de recogida a domicilio o en las instalaciones del cliente. Esto no solo facilita el proceso para el usuario, sino que también asegura que las muestras sean transportadas en condiciones óptimas, minimizando el riesgo de degradación o contaminación antes de llegar al laboratorio. La celeridad en la recogida es crucial, especialmente cuando se trata de análisis que requieren la preservación de la viabilidad bacteriana.
Cancelación de Análisis: Procedimientos y Costes
En lo que respecta a la cancelación de los análisis solicitados, existen unos protocolos establecidos. Las muestras que ya han iniciado su proceso de análisis en el laboratorio no pueden ser anuladas. Sin embargo, para aquellos análisis que han sido solicitados pero cuyas muestras aún no han sido procesadas, se contempla la posibilidad de anulación. En estos casos, cuando las muestras han sido registradas pero el análisis no ha comenzado, se aplica un coste administrativo de 10 euros por muestra anulada. Es importante que los usuarios estén al tanto de estas políticas para evitar sorpresas y gestionar sus solicitudes de análisis de manera eficiente.
Análisis Fisicoquímicos y Microbiológicos: Un Diagnóstico Completo
El análisis del agua no se limita a la detección de Legionella. Se abarcan también análisis fisicoquímicos y microbiológicos de aguas continentales, tanto tratadas como no tratadas. En el ámbito agronómico, por ejemplo, se analiza el agua de riego para detectar y cuantificar una amplia gama de contaminantes, incluyendo más de 500 plaguicidas, herbicidas y fungicidas, empleando técnicas avanzadas como la extracción en fase sólida (SPE).
La seguridad del agua de consumo es una prioridad, y en zonas con riesgo natural de radiactividad, se realizan análisis para detectar su posible presencia. Estos análisis son considerados esenciales para garantizar la calidad y seguridad del agua que llega a los hogares y a las explotaciones agrícolas.
Además, la medición de parámetros como el pH y la conductividad en agua o suelo es fundamental para completar cualquier diagnóstico agronómico. Estos parámetros, aunque sencillos de medir, proporcionan información crucial sobre las condiciones del medio y la disponibilidad de nutrientes, siendo un complemento perfecto para análisis más exhaustivos. El pH, en particular, es un indicador esencial que determina la idoneidad del agua para diversos usos y afecta tanto a la viabilidad de las bacterias como a la eficacia de los tratamientos químicos.

La turbidez, medida en Unidades Nefelométricas de Fomación (UNF), indica la presencia de partículas en suspensión. Niveles altos de turbidez no solo se asocian con la posible presencia de microorganismos patógenos, sino que también son un reflejo de la eficacia de los sistemas de filtración. El control del cloro libre y combinado es determinante para evaluar la efectividad de la desinfección del agua. Un exceso de cloro puede, de hecho, interferir en los resultados de los cultivos microbiológicos, generando falsos negativos.
La presencia de hierro en el agua, especialmente si el sistema dispone de partes metálicas, es otro factor a considerar. El hierro puede favorecer el crecimiento de Legionella, convirtiéndose en un aliado para su proliferación. Por ello, su control y monitorización son parte integral de una estrategia de prevención efectiva.
El Cultivo de Legionella: Métodos y Consideraciones
Desde el descubrimiento de Legionella pneumophila, se han desarrollado diversos medios de cultivo para su aislamiento y propagación. La base de estos medios suele estar compuesta por extracto de levadura, carbón activo y agar. Esta base, tamponada con ACES y suplementada con pirofosfato férrico, L-cisteína y Cetoglutarato, proporciona los nutrientes necesarios para el crecimiento de las legionelas.
Para hacer estos medios selectivos, se utilizan suplementos específicos. El suplemento GVPC, descrito por Dennis y colaboradores, es uno de ellos. Contiene Glicina y antimicrobianos que favorecen tanto el crecimiento como el aislamiento y la enumeración de estas bacterias, especialmente en muestras poco contaminadas o aguas potables. Las colonias de Legionella suelen presentar un aspecto blanco grisáceo o azulado, aunque puede variar ligeramente según la especie. Para una identificación presuntiva, las colonias se resiembran en el medio BCYE y en agar sangre (TSA), observándose crecimiento únicamente en el primer medio.
Antes de la siembra, es recomendable que las placas de cultivo alcancen la temperatura ambiente. La superficie del medio debe estar húmeda, pero no excesivamente mojada. La incubación se realiza a una temperatura de 36±2ºC en una atmósfera con un 5% de CO2. Es importante recordar que diversas especies de Legionella son potencialmente patógenas para el ser humano. Las placas cultivadas deben conservarse a temperaturas entre 4-15ºC, protegidas de la luz mediante su embalaje.
El marco legal actual, como el RD 865/2003, estipula que la técnica de detección de Legionella debe realizarse por cultivo. Sin embargo, este método presenta desafíos. Pueden surgir problemas con muestras que contienen un exceso de sedimentos, los cuales pueden obstruir los filtros. En ocasiones, se reciben muestras de aguas aparentemente limpias que provienen de instalaciones donde se han añadido productos químicos para mantener los sólidos en suspensión y evitar la formación de sedimentos en la red. Estos procedimientos, aunque buscan prevenir problemas de obstrucción, pueden complicar el análisis microbiológico.
El cultivo de la bacteria de Legionella implica la inoculación de diferentes fracciones de la muestra sobre agar. El objetivo es aislar y cuantificar Legionella (células vivas) en muestras ambientales. Estos ensayos son laboriosos y permiten determinar subespecies y serotipos de Legionella.
Técnicas de Detección Rápida: La PCR y la Filtración por Membrana
Frente a la laboriosidad y el tiempo requerido por el cultivo, existen técnicas de detección rápida, como la Reacción en Cadena de la Polimerasa (PCR). La técnica PCR permite obtener resultados en tan solo 24 horas, mediante la extracción y purificación del ADN de las células bacterianas.
En el ámbito de la microbiología del agua, la detección precisa de Legionella es crucial. Dorsan, por ejemplo, ofrece membranas de microfiltración de alta calidad que contribuyen a mejorar los estándares de análisis. El procedimiento recomendado para la detección de Legionella implica la filtración a través de membranas de nitrocelulosa (NC), polietersulfona (PES) o policarbonato (PCTE), con un tamaño de poro entre 0.2 y 0.4 μm.

La Directiva (UE) 2020/2184 sobre la calidad de las aguas destinadas al consumo humano ha puesto un mayor énfasis en la gestión del riesgo y la prevención de brotes asociados a Legionella. El proceso de detección de Legionella comienza con una adecuada toma de muestras, un paso crítico para obtener resultados fiables.
Según la norma ISO 12869, para la detección y cuantificación de Legionella por PCR, es necesario filtrar al menos 50 mL de agua (cuanto mayor volumen, mejor límite de detección) a través de un filtro de membrana de policarbonato con un tamaño de poro de 0.45 µm o menos.
El análisis de Legionella, siguiendo la norma ISO 11731:2017, es un proceso que puede requerir entre 7 y 10 días para la obtención de resultados. El Anexo J de esta norma detalla que la elección de los medios de cultivo depende del tipo de muestra y de la carga bacteriana presente.
Durante el proceso de filtración de la muestra, es fundamental evitar que el filtro se seque, ya que esto podría comprometer la viabilidad de las bacterias. Asimismo, el tratamiento de la muestra con ácido o calor debe realizarse con precaución. Un tiempo o temperatura excesivos pueden afectar la supervivencia de Legionella, reduciendo la capacidad de detección e incluso matando todas las células viables. La siembra y la incubación deben llevarse a cabo en un ambiente aséptico para minimizar el riesgo de contaminación.
Video explicativo para toma de muestra de agua para control de legionella
Empresas como Bioser trabajan continuamente para ofrecer soluciones eficaces, fiables y adaptadas a las exigencias normativas, incluyendo la posibilidad de detectar y discriminar en un único ensayo tanto Legionella spp. como L. pneumophila y L. longbeachae. La combinación de métodos de cultivo y técnicas moleculares, junto con un riguroso control de los parámetros fisicoquímicos del agua, es la clave para una gestión integral y efectiva del riesgo asociado a Legionella. La temperatura del agua, el pH, la turbidez y la presencia de cloro libre y combinado son factores que interactúan y determinan la viabilidad de la bacteria y la eficacia de los tratamientos.
tags: #placa #legionella #filtracion #aguas